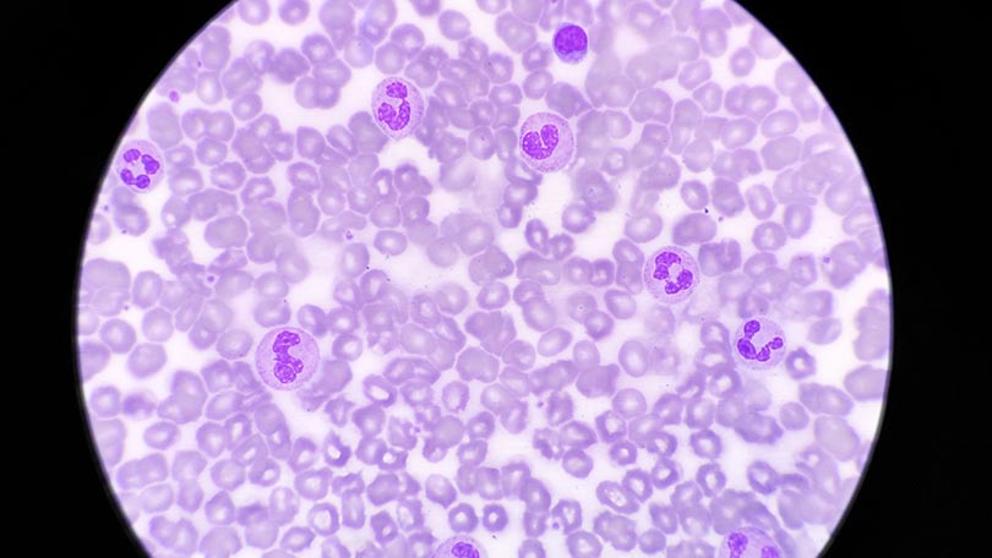

El nolotil se enmarca por ser un medicamento bastante recurrente por las personas, siendo el nombre comercial con el cual se distribuirá el principio activo metamizol, cuyo efecto es adecuado para erradicar el dolor y disminuir la fiebre. Es importante señalar, que en las recientes semanas el medicamento ha sido objeto de polémica, esto devenido por el fallecimiento de diez británicos que consumieron el fármaco estando en España.
Según las fuentes médicas, las razones de la muerte se debieron al surgimiento de agranulocitosis, que es identificado como el efecto más traumático que genera su medicación. Dicha consecuencia para el bien de la humanidad, suele presentarse esporádicamente.
2El riesgo más grande del nolotil: La agranulocitosis
El problema mas serio que puede desprenderse del metanizol, es el riesgo referente al surgimiento de agranulocitosis, que se caracteriza por ser una enfermedad que repercutirá negativamente a la sangre. Es imprescindible señalar, que es te efecto secundario no es para nada nuevo, lo que sucede según palabras del especialista es: «su relación de causalidad con la toma del fármaco es bien conocida».
La manifestación del aglunulocitosis es que genera una especie de reacción alérgica o autoinmune, la cual estará íntimamente conectada con la ingesta de metamizol. De esta manera, tanto los leucocitos como los neutrófilos de los pacientes disminuirán en gran medida, condiciendo que sus organismos experimenten ausencia de defensas.
El doctor Palop argumenta: «Debido a esta disminución de las defensas, este efecto adverso puede ser mortal, ya que cualquier infección banal puede progresar a una sepsis. Pero hay que recordar que no es un efecto secundario frecuente».
Teniendo en consideración todos los estudios elaborados en España, la presencia de la agranulocitosis puede depender según la población en que este expuesta: «En nuestro país su aparición es más rara. Por ejemplo, según los estudios que se han hecho en Cataluña, puede aparecer en uno de cada millón de pacientes que lo tomen. Mientras que en las investigaciones realizadas en países como Suecia, antes de su retirada, la afectación era de uno de cada 1.439», constata el especialista medico Vicente Palop.
El doctor conecta las investigaciones formuladas con las muertes de los ciudadanos británicos: “La población inglesa y la escandinava también tienen mayor riesgo, aunque no se ha cuantificado».



